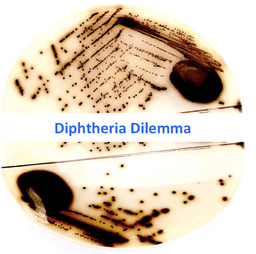
Diphtheria Dilemma

Multimorbidity
Published in Healthcare & Nursing
Over the last few decades, health systems have become increasingly focused on sub-specialties with care organised around disciplines based on body systems. Meanwhile, more and more patients live with multiple ongoing conditions, referred to as multimorbidity. We know that having multimorbidity worsens health outcomes, reduces quality of life and increases what is called treatment burden, i.e, the work that a person has to do to manage their health conditions. We also know that multimorbidity is putting increasing pressure on health systems globally, which are poorly designed to address it. We are a group of multidisciplinary clinicians and researchers from high, middle and low income countries who wanted to bring together all the latest evidence on multimorbidity. To do this, myself and co-authors Søren Skou, Frances Mair, Martin Fortin , Bruce Guthrie, Bruno Nunes, J. Jaime Miranda, Cynthia M. Boyd, Sanghamitra Pati and Sally Mtenga wrote a Nature Reviews Disease Primer on Multimorbidity that considered epidemiology, mechanisms, diagnosis and management (rdcu.be/cRBzm).
The epidemiology highlights the increasing prevalence of multimorbidity and the challenges ahead of us. While many associate it with older patients, in absolute terms there are more middle aged people with multimorbidity and in high income countries, those living in the most disadvantaged communities develop it at an earlier age and experience more complex combinations of physical and mental health conditions. This may be explained by some of the socioeconomic, behavioural and biological determinants we identified underpinning its development, which is also closely linked to polypharmacy. Many of these mechanisms are interrelated and have synergistic effects across the lifespan. The evidence from low and middle income countries (LMICs) also suggests that multimorbidity is an increasing problem but it is more prevalent in more affluent groups which likely relates to access to formal healthcare. Overall, there is very little evidence around prevention of multimorbidity. Meanwhile, the impact for patients is a mix of increasing treatment and disease burden, which diminishes their capacity to manage and increases the need for an approach to care that explicitly accounts for multimorbidity.
The review also highlights the lack of clear evidence for interventions for multimorbidity despite a number of existing reviews including up to 16 randomised trials. These trials were all conducted in high income countries and overall, there was a lack of evidence supporting management in LMICs, where multimorbidity is compounded by additional pressures such as poverty and weaknesses in health systems. There are undoubtedly challenges conducting trials in multimorbidity but we need evidence to inform clinical guidelines and practice. The key message for clinicians from the small number of available guidelines is to shift perspective and adopt a multimorbidity approach to care.
In conclusion, we achieved our objective of pulling together a comprehensive overview of current multimorbidity evidence. The key message is how much more we need to learn. There is an urgent need to identify effective prevention strategies, likely based around healthy behaviours and to reorientate our health and social care systems to address the challenges faced by the increasing number of people across the world living with multimorbidity.
Follow the Topic
-
Nature Reviews Disease Primers

This journal provides a global overview of the field and outlines key open research questions. Primers have a modular structure, covering epidemiology; disease mechanisms; diagnosis, screening and prevention; management; and quality of life.

Please sign in or register for FREE
If you are a registered user on Research Communities by Springer Nature, please sign in